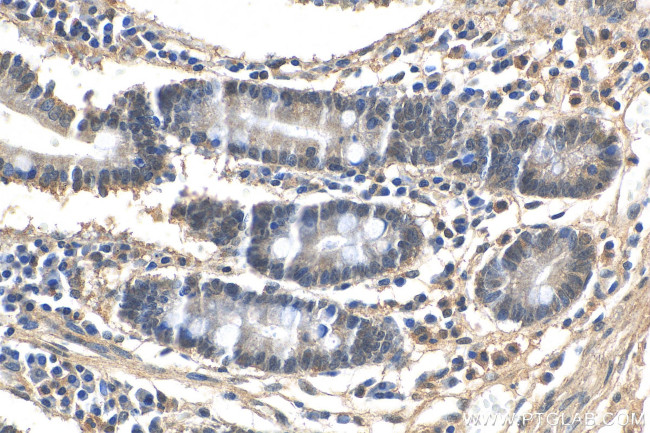
LSM6 Antibody in Immunohistochemistry (Paraffin) (IHC (P))

Search
Proteintech
LSM6 Polyclonal Antibody
{{$productOrderCtrl.translations['antibody.pdp.commerceCard.promotion.promotions']}}
{{$productOrderCtrl.translations['antibody.pdp.commerceCard.promotion.viewpromo']}}
{{$productOrderCtrl.translations['antibody.pdp.commerceCard.promotion.promocode']}}: {{promo.promoCode}} {{promo.promoTitle}} {{promo.promoDescription}}. {{$productOrderCtrl.translations['antibody.pdp.commerceCard.promotion.learnmore']}}
产品信息
12138-1-AP
种属反应
宿主/亚型
分类
类型
抗原
偶联物
形式
纯化类型
保存液
内含物
保存条件
运输条件
产品详细信息
Immunogen sequence: MSLRKQTPSD FLKQIIGRPV VVKLNSGVDY RGVLACLDGY MNIALEQTEE YVNGQLKNKY GDAFIRGNNV LYISTQKRRM
靶标信息
Sm-like proteins were identified in a variety of organisms based on sequence homology with the Sm protein family (see SNRPD2; MIM 601061). Sm-like proteins contain the Sm sequence motif, which consists of 2 regions separated by a linker of variable length that folds as a loop. The Sm-like proteins are thought to form a stable heteromer present in tri-snRNP particles, which are important for pre-mRNA splicing.
仅用于科研。不用于诊断过程。未经明确授权不得转售。
篇参考文献 (0)
生物信息学
蛋白别名: LSM6 homolog, U6 small nuclear RNA associated; LSM6 U6 small nuclear RNA and mRNA degradation associated; Sm protein F; U6 snRNA-associated Sm-like protein LSm6; unnamed protein product
基因别名: LSM6; YDR378C
UniProt ID: (Human) P62312
Entrez Gene ID: (Human) 11157